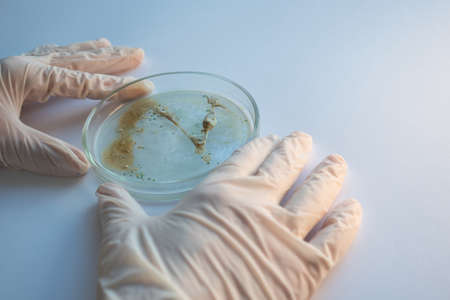
epidemic and the global virus attack concept. lab technician or researcher holds a Petri dish with a sample. Virology and bacteriologyの写真素材

写真素材 - epidemic and the global virus attack concept. lab technician or researcher holds a Petri dish with a sample. Virology and bacteriology
作品情報
epidemic and the global virus attack concept. lab technician or researcher holds a Petri dish with a sample. Virology and bacteriology
- ID:156471536
- 作品種別:写真
- 作者名:Yulia Koltyrina
キーワード
- Petri dish
- Virology
- advanced
- analysis
- bacteria
- bacterial
- bacteriology
- biochemistry
- biological
- biology
- biotechnology
- concept
- culture
- dish
- epidemic viral pathogen
- equipment
- glassware
- gloves
- grow
- hands
- health care
- human
- hygiene
- infection
- lab
- laboratory
- laboratory assistant
- medical
- microbe
- microbiology
- microorganisms
- pandemic
- petri
- research
- sample
- science
- scientific
- scientific research
- scientist
- symbol
- test
- viral
- virus attack
- viruses
類似作品
Business woman ...
coronavirus pin...
Mans hand holds...
coronavirus on ...
Covid-19 virus ...
Displaying digi...
earth with crum...
Map highlights ...
Covid-19 virus ...
Hand hacking ta...
Corona virus wi...
The concept of ...
A detailed worl...
Computer screen...
Laptop screen s...
Image of bauble...
Digital illustr...
pandemic concep...
Conceptual hand...
3D-Illustration...
Ncov 2019 covid...
Coronavirus Dis...
New Coronavirus...
Highlighted zon...
Ukrainian and R...
coronavirus pin...
Hand holding an...
Coronavirus Asi...
cell spread aro...
Atomic nucleus ...
2019 ncov covid...
3D illustration...
Visualization s...
Highlighted zon...
Coronavirus Aro...
A computer moth...
world map red C...
Visual represen...
Scientific visu...
Visual represen...
Illustration of...
global with blo...
A computer scre...
Epidemic or vir...
New coronavirus...
Dangerous coron...
Computer screen...